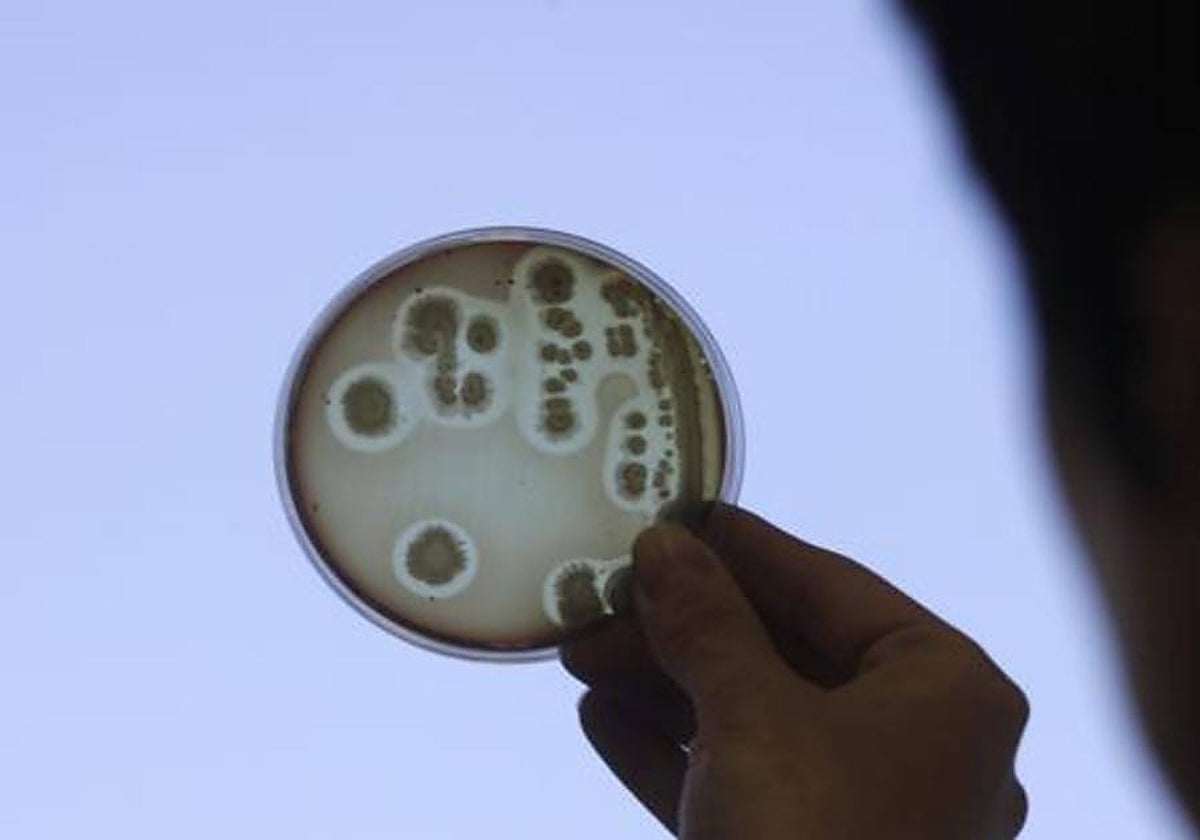
Las bacterias, como las de la imagen, podrían contener el secreto de una nueva fuente de energía limpia

Energía casi de la nada: hallan una enzima que convierte el aire en electricidad
Presente en bacterias comunes que pueden sobrevivir incluso en entornos muy hostiles, este descubrimiento tiene potencial para convertirse en una nueva fuente limpia
Científicos españoles resucitan partes de bacterias de hace 2.600 millones de años que podrán curar enfermedades genéticas
P. Biosca
Madrid
Aunque normalmente relacionemos las bacterias con enfermedades, lo cierto es que este grupo posee una suerte de 'superpoderes' que van desde 'autovacunarse' a comer plásticos, pasando por sobrevivir en entornos tan hostiles como el espacio. También son expertas en conseguir energía ... casi de la nada: los científicos saben desde hace tiempo que muchas son capaces de generar electricidad del aire en entornos tan hostiles como los volcanes o los polos. Sin embargo, se desconocía el sistema que empleaban para ello. Ahora, investigadores australianos han descubierto la enzima responsable de esta 'mágica' transformación, y dicen que su hallazgo es un primer paso para crear baterías naturales que produzcan energía limpia.
El equipo, dirigido por Rhys Grinter, Ashleigh Kropp y Chris Greening, investigadores del Instituto de Descubrimiento de Biomedicina de la Universidad de Monash en Melbourne (Australia), ya demostró que muchas bacterias utilizan el hidrógeno de la atmósfera como fuente de energía en entornos pobres en nutrientes; es decir, con tan solo 'respirar', incluso en lugares hostiles para la vida, generan electricidad que les ayuda a sobrevivir.
«Sabemos desde hace algún tiempo que las bacterias pueden usar las trazas de hidrógeno en el aire como fuente de energía para ayudarlas a crecer, incluso en los suelos antárticos, los cráteres volcánicos y las profundidades del océano», explica Greening. «Pero no sabíamos cómo lo hacían. Hasta ahora». Los resultados de su nueva investigación acaban de publicarse en la revista 'Nature'.
El secreto de Huc
El equipo se centró en una enzima de la bacteria Mycobacterium smegmatis. Llamada Huc, convierte el hidrógeno gaseoso en una corriente eléctrica. «Huc es extraordinariamente eficiente -señala Grinter -. A diferencia de todas las demás enzimas y catalizadores químicos conocidos, consume hidrógeno por debajo de los niveles atmosféricos, tan solo el 0,00005 % del aire que respiramos».
«No usar las nuevas técnicas de mejora genética en agricultura es como si un cirujano operase con serrucho teniendo bisturí»
Patricia BioscaLa tecnología Crispr, que consigue plantas más resistentes o frutos más productivos, se utiliza cada vez más
Los investigadores utilizaron varios métodos para revelar el modelo molecular de la oxidación del hidrógeno atmosférico. Utilizaron microscopía avanzada (crio-EM) para determinar su estructura atómica y vías eléctricas, superando los límites establecidos anteriormente para producir la estructura enzimática más resuelta reportada por este método hasta la fecha. También usaron una técnica llamada electroquímica para demostrar que la enzima purificada crea electricidad en concentraciones mínimas de hidrógeno.
En el laboratorio demostraron, además, que es posible almacenar Huc purificado durante períodos prolongados. «Es asombrosamente estable. Es posible congelar la enzima o calentarla a 80 grados centígrados y conserva su poder para generar energía -explica Kropp-. Esto refleja que esta enzima ayuda a las bacterias a sobrevivir en los ambientes más extremos».
Huc es una 'batería natural' que produce una corriente eléctrica sostenida a partir de aire o si se le agrega hidrógeno. Los autores señalan que, si bien esta investigación se encuentra en una etapa inicial, el descubrimiento de esta enzima tiene «un potencial considerable para desarrollar pequeños dispositivos impulsados por aire, por ejemplo, como una alternativa a los dispositivos alimentados por energía solar».
Posibilidad de cultivo
La siguiente pregunta es obvia: ¿de dónde podemos sacar más de este Huc que produce electricidad de la nada? Los autores dicen que no solo de Mycobacterium smegmatis se extrae esta enzima: otras bacterias comunes tienen enzimas parecidas y se pueden cultivar en grandes cantidades, «lo que significa que tenemos acceso a una fuente sostenible de la enzima», señalan.
«Una vez que producimos Huc en cantidades suficientes, el cielo es literalmente el límite para usarlo para producir energía limpia», señala Grinter.
Esta funcionalidad es sólo para suscriptores
Suscribete
Esta funcionalidad es sólo para registrados
Iniciar sesiónEsta funcionalidad es sólo para suscriptores
Suscribete